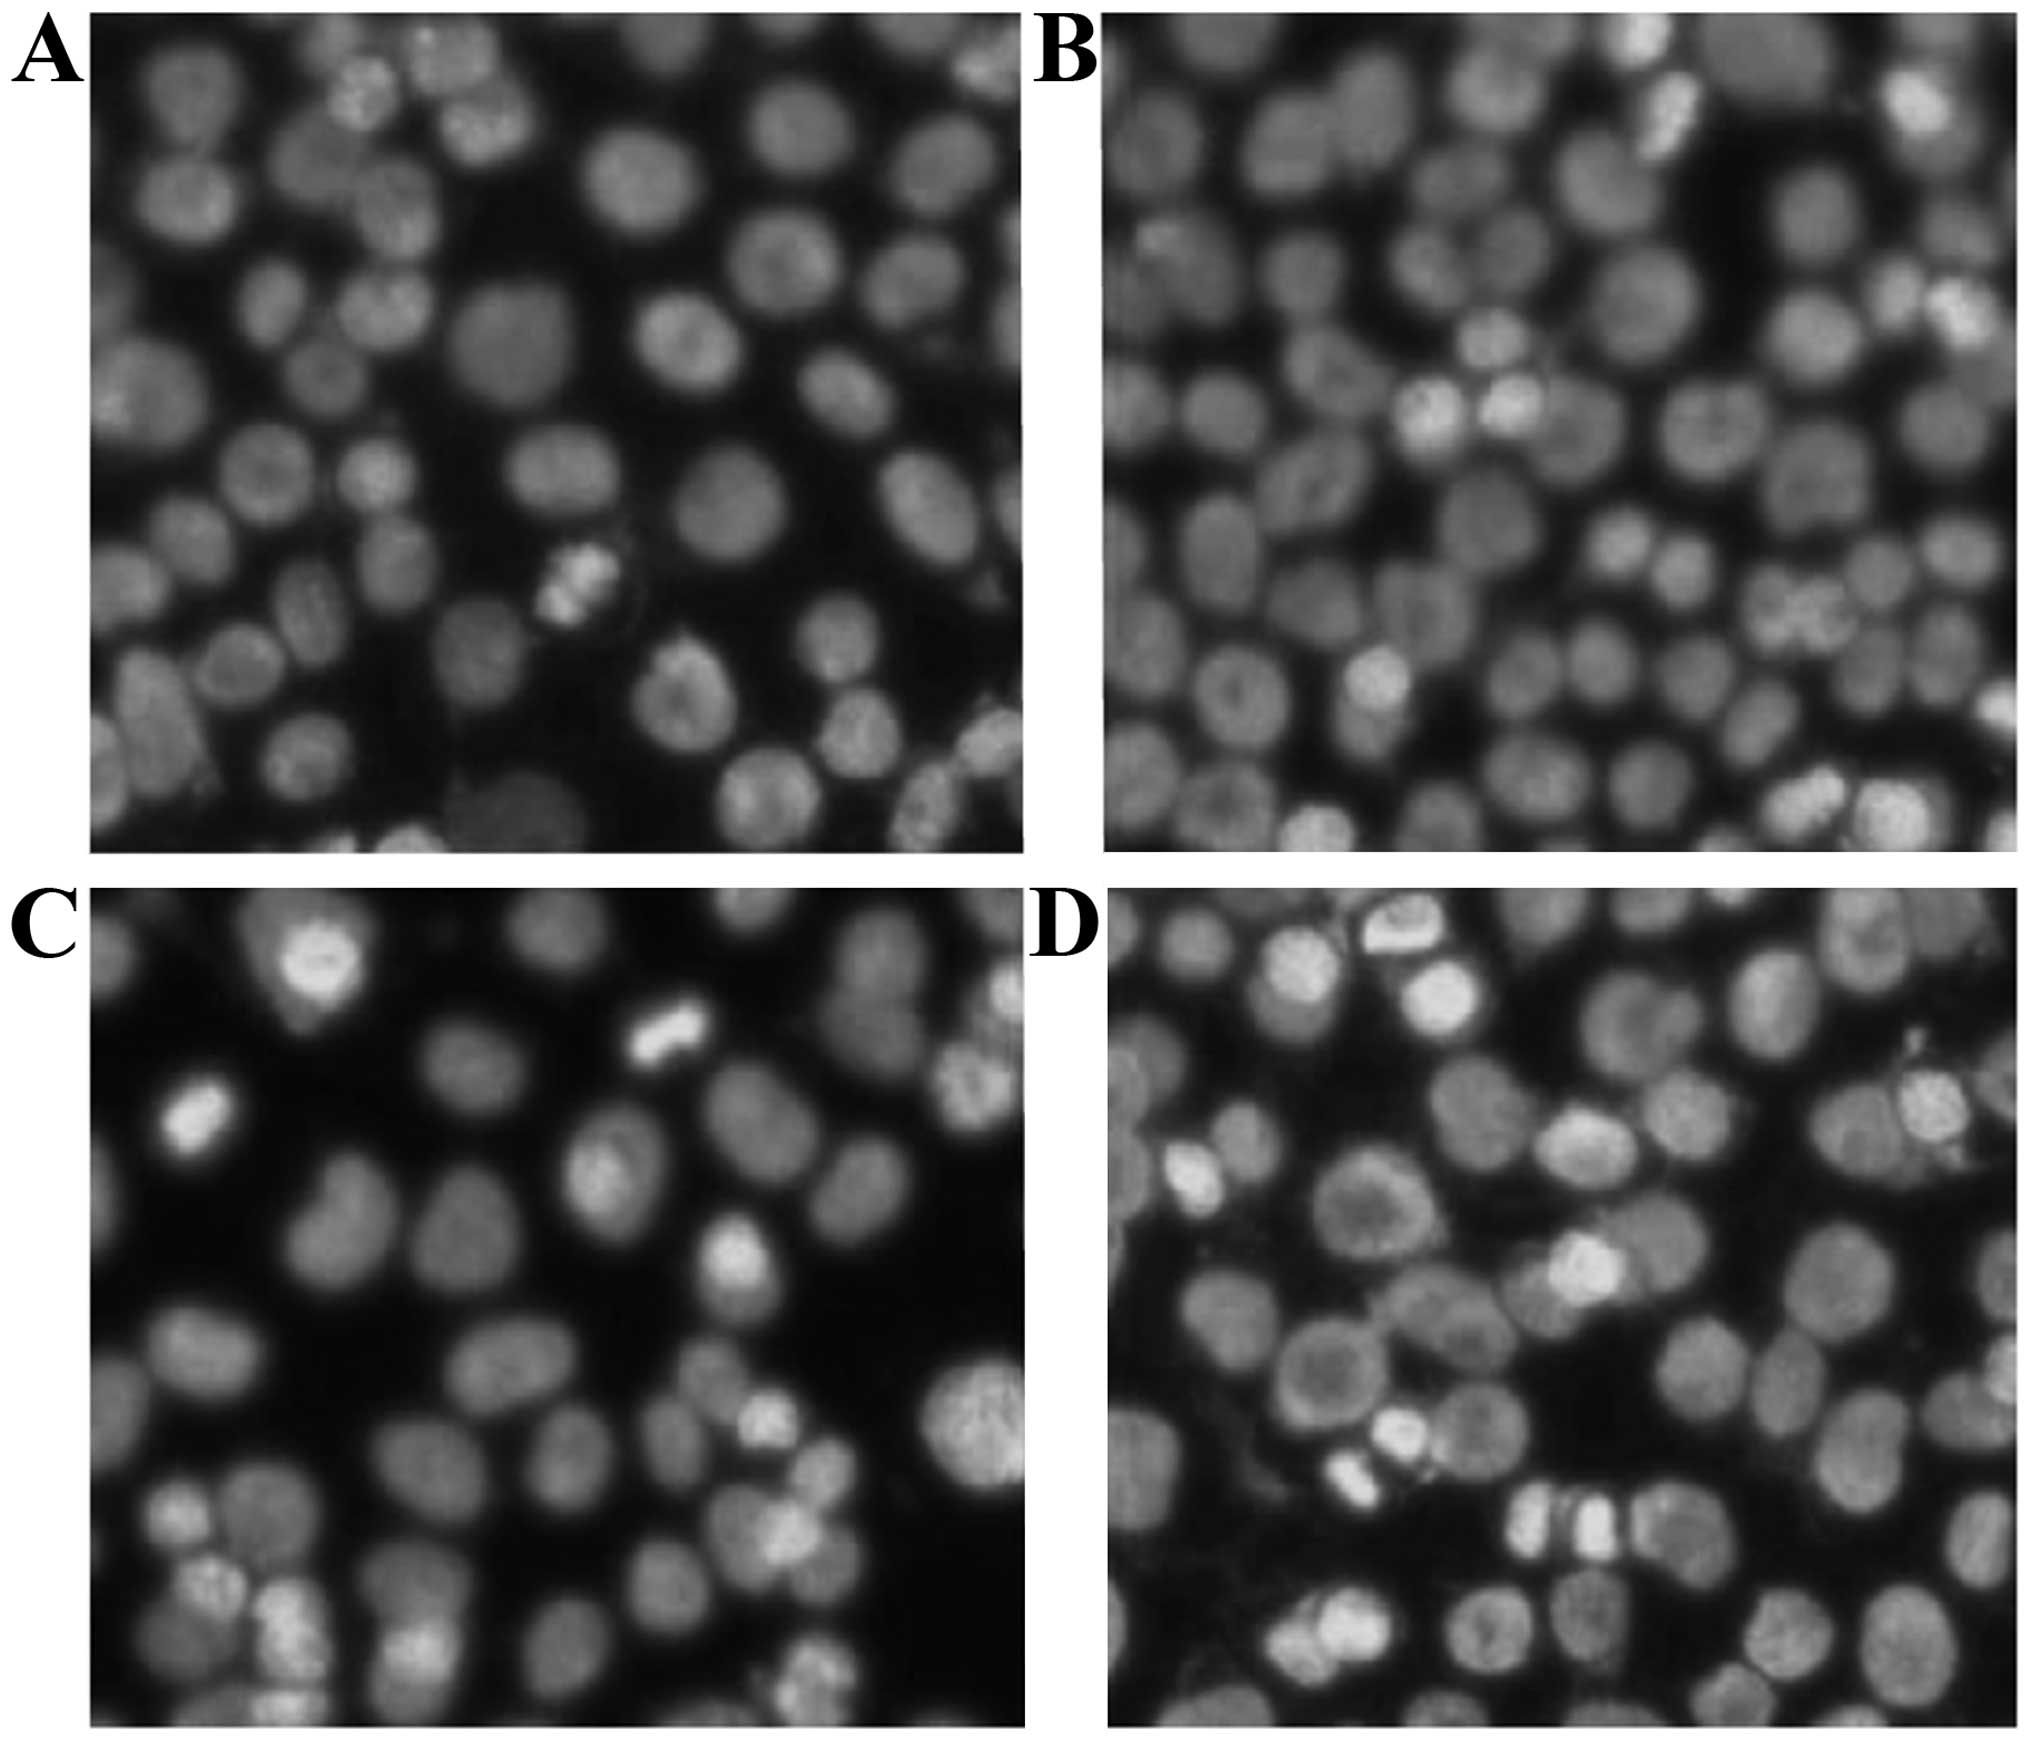

Introduction
Esophageal cancer is a malignant tumor, and is the
leading cause of morbidity and mortality in certain areas of China.
The prognosis of patients with esophageal carcinoma is poor, with a
5-year overall survival rate of ~10% for advanced esophageal cancer
(1). In order to control the spread
of cancer and to find an effective integrated therapeutic
treatment, the clinical treatment of esophageal cancer using
potential novel drugs has become a focus of research attention,
although surgical treatment remains the primary therapy (2,3). Recently,
a number of novel drugs, including taxol, oxaliplatin and
irinotecan, have been used for the treatment of esophageal cancer,
providing impetus for the research and development of novel
antitumor agents.
The dried flowers of Trollius chinensis Bunge
have been used as a traditional Chinese medicine for a long time.
The plant grows widely throughout Southwest, Northwest and
Northeast china (4). The plant is
used to reduce swelling and promote good eyesight, and is
clinically approved for antibacterial and antiviral treatments
(5–7).
Previous studies have shown that the total flavonoids in
Trollius chinensis possess anticancer activity, however, the
mechanisms have not been elucidated (8–10).
Orientin and vitexin are the monomer components of total flavonoids
in Trollius chinensis. The content of orientin and vitexin,
which belong to the flavone C-glycoside class, is higher in the
flavone of Trollius chinensis (11–13).
Orientin possesses antithrombus and antioxidant abilities, and
protects against myocardial ischemic-anoxic injuries (14–16).
Vitexin has strong antioxidant and antiviral effects (17,18).
Orientin and vitexin have the same chemical constitution as
cyanidenon and apigenin, which are anticancer agents (Fig. 1) (19).
As such, we hypothesized that orientin and vitexin have marked
antitumor capacities. Flavone C-glycosides have stronger
anti-inflammatory effects in vitro than flavonoids.
Moreover, the structure of flavone C-glycosides affects their
anti-inflammatory activity (20). The
difference between orientin and vitexin is that orientin has a
phenolic hydroxyl group at the 3′ of the B ring (21); it is therefore worth considering how
this architectural difference affects the antineoplastic activity
of orientin and vitexin. There are currently no studies regarding
the effects of orientin and vitexin on the induction of apoptosis
in esophageal cancer cells in vitro. In the present study,
EC-109 cells were used for the comparison of the effects of
orientin and vitexin in a broad attempt to investigate their
antitumor capacities.
Materials and methods
Reagents
Wild Trollius chinensis was identified by
Professor Shulan Ma, who works in the Institute of Materia Medica
(Hebei North University, Zhangjiakou, Hubei, China). Dried flowers
of Trollius chinensis were collected from Guyuan,
Zhangjiakou, Hebei, China.
First, a high-performance liquid chromatography
method (Agilent 1100 high performance liquid chromatograph; Agilent
Technologies Inc., Santa Clara, CA, USA) was developed for the
determination of the purity of orientin and vitexin. The column was
a Hypersil BDS C18 (4.6×150-mm, 5-µm) column (Thermo Fisher
Scientific Inc., Waltham, MA, USA) that used an acetonitrile:acetic
acid (15:85) solution as the mobile phase and a flow rate of 1.0
ml/min. The column temperature was set to 30°C. The detection
wavelength was 340 nm. A preparative high-performance liquid
chromatography method was also established for purifying the
orientin and vitexin. The column was a ZORBAX SB-C18 (21.2×250-mm,
7-µm) column (Agilent Technologies Inc.) that used an
acetonitrile:acetic acid (15:85) solution as the mobile phase and a
flow rate of 20 ml/min. The column temperature was set to 25°C. The
detection wavelength was 340 nm. A fraction was collected based on
the peak, with a minimum threshold of 2.2. Nuclear magnetic
resonance spectroscopy was used by the Chinese Academy of Sciences
Nuclear Magnetic Resonance Institute, Beijing, China) to identify
the structure of orientin and vitexin. High-performance liquid
chromatography was used for the quantitative analysis of orientin
and vitexin. The purities of orientin and vitexin were found to be
98.9 and 98.6%, respectively (Fig.
2).
MTT was purchased from Shanghai Mazhijia Corporation
(Shanghai, China). The Hoechst Staining kit was purchased from
Beyotime Institute of Biotechnology (Shanghai, China) and the
Annexin-FITC Apoptosis Detection kit was manufactured by Jingmei
Biological Engineering Corporation (Shenzhen, China). Agarose and
the 100-bp DNA marker were obtained from Beijing Liuhetong
Corporation (Beijing, China). Fetal bovine serum was manufactured
from Hangzhou Sijiqing Bio-engineering Material Co., Ltd.
(Hangzhou, China). Fluorescein isothiocyanate (FITC)-p53 and
phycoerythrin-B-cell lymphoma-2 (PE-bcl-2) were purchased from BD
Biosciences (Franklin Lakes, NJ, USA). Trypsin was bought from the
North China Pharmaceutical Group (Shijiazhuang, China) and dimethyl
sulfoxide (DMSO) was obtained from Beijing Chemical Reagent Factory
(Beijing, China). The EC-109 cells were purchased from the National
Cancer Institute of Beijing (Beijing, China).
Cell culture and grouping
Esophageal cancer EC-109 cells were grown in
RPMI-1640 medium (Gibco Life Technologies, Carlsbad, CA, USA), the
pH of which was adjusted to 7.2–7.4 with sodium bicarbonate, and
supplemented with 10% fetal calf serum (Hangzhou Sijiqing
Biological Engineering Material Co., Ltd.) and gentamycin (100
U/ml; North China Pharmaceutical Group) in an incubator with 5%
CO2 at 37°C under saturated humidity. Subsequent to
being cultured for 24 h, the cells were observed under a
reverse-phase microscope (Eclipse Ti-U; Nikon, Tokyo, Japan). Clear
cells adhering to the wall appeared to exhibit a spindle shape,
which indicated they were in good condition. The cells were
trypsinized with a 1:3 solution of (0.25%) trypsin (North China
Pharmaceutical Group) plus (0.02%) EDTA (Beijing Chemical Reagent
Factory), until the cells reached 80% confluence and were passaged.
The cell cultures and experiments were performed in a sterile
environment. Throughout the experiments, cells in the exponential
growth phase were used.
The cells were split into four groups as follows:
The orientin- and vitexin-treated groups (final concentrations of
5.0, 10.0, 20.0, 40.0 and 80.0 µM for each group), a blank group
(identical quantities of cell culture fluid to the drug-treated
group), and a solvent control group (cell culture fluid containing
DMSO, with a final concentration of 0.2%).
Growth inhibition assay
The effect of orient and vitexin on the growth and
survival of the EC-109 cells was determined by the MTT assay.
Orientin and vitexin are insoluble in water. Using DMSO as the
cosolvent, orientin or vitexin were diluted with culture medium.
The cells were observed after exposure to the drugs at different
concentrations for 24, 48 and 72 h. The experiments for the two
control groups and the two drug-treated groups were repeated 5
times without exception. Exponentially growing EC-109 cells were
harvested, counted and the cell concentration adjusted. A total of
100 µl single cell suspension was plated at 5×104 cells
per well in 96-well plates for 24 h. Following cell adherence, the
medium in the plates was substituted with 100 µl of each drug at
the different concentrations, diluted with culture fluid according
to grouping. An equal amount of culture liquid was added to the
blank control group, whereas an equal amount of culture liquid
supplemented with DMSO to a final concentration of 0.2% was added
to the solvent control group. Following incubation for 24, 48 or 72
h, 20 µl of MTT stock solution was added to each well and the
plates were further incubated for 4 h at 37°C. A microplate reader
(Spectra Max M2; Molecular Devices Corporation, Silicon Valley, CA,
USA) was adopted to measure absorbance with a wavelength of 450 nm.
The average inhibition rate of the cancer cells treated with
orientin and vitexin was calculated as follows: Inhibition rate =
(absorbance of blank control group - absorbance of drug group /
absorbance of blank control group) × 100.
Hoechst 33258 staining to observe
EC-109 cellular morphology
A total of 900 µl of EC-109 cells was seeded at
5×103 cells per well into 24-well flat-bottomed plates.
Once incubated for 6 h, the adherent cells was subjected to
different concentrations of either orient or vitexin at 5.0, 20.0
or 80.0 µM. The blank group was not treated. Following incubation
for 48 h, the results were processed using an excitation wavelength
of 340 nm. Microscopy (ECLIPSE Ti-U; Nikon, Tokyo, Japan) was
adopted for observation of the results and images were
captured.
Agarose gel electrophoresis
The cells were plated in a 20-ml culture bottle at
1×106/ml. Over time, the cells were treated with the
drugs. The final concentration of orientin and vitexin was 5.0,
20.0 and 80.0 µM in each group. The blank control group was also
set up. The cells were harvested after a 48-h culture and washed
three times using phosphate-buffered saline (PBS). The cells were
transferred into 1.5-ml Eppendorf tubes and mixed with lysis
buffer, prior to being agitated in a water bath at 70°C (two times
for 15 min). Centrifugation (9,590.4 × g) was performed and
absolute ethyl alcohol was added into the supernatant to
precipitate the DNA. After centrifugation (9,590.4 × g) of the
solution obtained above, 20 µl TE buffer (pH 7.4) was adopted to
dissolve DNA. Agarose gel electrophoresis was performed using
DYDP-31A agarose electrophoresis apparatus (Beijing LiuYi
Instrument Factory, Beijing, China) in accordance with the
manufacturer's instructions. Prior to the electrophoresis, RNase
was added into the buffer obtained above. The 2% agarose gel
electrophoresis last for 60 min, and was observed, with images
captured, using the gel imaging and analysis system (BioSpectrum AC
system; UVP, Upland, CA, USA).
FCM to detect early apoptotic
cells
The experimental group and the exposed time were the
same as for the ‘Agarose gel electrophoresis’ section. Five
parallel samples were set up for each group. The EC-109 cells
(1×106) of the control and drug groups were harvested,
centrifuged (374.6 × g) and the supernatant aspirated, prior to
being washed twice with PBS.
Apoptosis was assessed using the Annexin V-FITC
Apoptosis kit (Jingmei Biological Engineering Corporation)
according to the manufacturer's instructions. Briefly, the cells
were mixed with 10 µl Annexin-V and 5 µl PI, and kept away from the
light for 20 min. The supernatant was discarded and the cells were
washed using PBS. The cells were then resuspended in 400 µl PBS.
FCM using FACS-Aria (BD Biosciences) was adopted to detect the
early apoptotic rate.
FCM to detect p53 and bcl-2 protein
expression
At a density of 1×106/ml, EC-109 cells in
the logarithmic growth phase were plated in a 20-ml culture bottle.
After a period of time, the adherent cells was treated as
appropriate for the blank control group, or with concentrations of
5.0, 20.0, 80.0 µM of orientin and vitexin, respectively. After 4
h, the cells were harvested and 20 µl FITC-p53 and PE-bcl-2 were
added for 20 min. The cells were then subjected to FCM.
Statistical analysis
The results are expressed as the mean ± standard
deviation, and data were tested by least significant difference
tests using SPSS software version 16.0 (SPSS, Inc., Chicago, IL,
USA). P<0.05 was used to indicate a statistically significant
difference.
Results
Inhibition effect of orientin and
vitexin in EC-109 cells
Experimental data from the present study showed that
DMSO hardly had any effect on cell activity (Table I), with a maximum inhibition ratio of
<1%, so the following experiments did not use a reagent control
group. The results of the study confirm that the growth inhibition
rate increased with increasing concentration of orientin and
vitexin (P<0.01). With increased treatment time, the inhibition
rates of orientin and vitexin at the same concentrations were
significantly increased (P<0.01). The inhibition rate in the
orientin-treated group was higher than that in the vitexin-treated
group at the same concentrations (P<0.01) (Table I). Previous studies showed that the
EC-109 inhibition ratio by Trollius chinensis flavonoids at
a concentration of 0.793 g/l for 24 h was 28.00% (7). The present study showed the inhibition
ratio of orientin and vitexin in EC-109 cells to be 34.08 and
20.08%, respectively, at 80.0 µM (0.0359 and 0.0356 g/l,
respectively), which indicated that orientin and vitexin may be
structural components that contribute to the efficacy of
Trollius chinensis flavonoids. In addition, the anticancer
activity of orientin and vitexin is superior to that of Trollius
chinensis flavonoids.
 | Table I.Inhibitory effect of orientin and
vitexin on EC-109 cells (mean ± standard deviation; n=5). |
Table I.
Inhibitory effect of orientin and
vitexin on EC-109 cells (mean ± standard deviation; n=5).
|
| Inhibition rate of
colony formation, % |
|---|
|
|
|
|---|
|
| 24 h | 48 h | 72 h |
|---|
|
|
|
|
|
|---|
| Concentration,
µM | Orientin | Vitexin | Orientin | Vitexin | Orientin | Vitexin |
|---|
| 5.0 |
5.23±0.12a–c |
2.24±0.11a–c |
10.82±0.23a–c |
4.82±0.33a–c |
18.38±0.16a–c |
8.28±0.36a–c |
| 10.0 |
8.03±0.20a–c |
3.67±0.26a–c |
21.06±0.32a–c |
8.06±0.32a–c |
36.65±0.56a–c |
14.65±0.56a–c |
| 20.0 |
14.35±0.43a–c |
8.35±0.44a–c |
30.02±0.88a–c |
15.02±0.30a–c |
48.78±0.58a–c |
26.70±0.52a–c |
| 40.0 |
20.43±0.51a–c |
13.43±0.51a–c |
36.90±0.67a–c |
21.90±0.60a–c |
51.04±0.66a–c |
33.04±0.63a–c |
| 80.0 |
34.08±1.16a–c |
20.08±1.16a–c |
44.60±1.45a–c |
31.60±1.45a–c |
58.80±1.11a–c |
38.30±1.24a–c |
| 0.2% DMSO |
0.66±0.23 |
0.66±0.23 |
0.58±0.15 |
0.58±0.15 |
0.49±0.44 |
0.49±0.44 |
Hoechst 33258 fluorescence tagging of
DNA to observe nuclear morphometry
The blank control cells had uniform round- or
oval-shaped nuclei with evenly distributed chromatin. Following
exposure to ultraviolet light, the cells exhibited homogeneous blue
fluorescence and areas of the cells at the division stage could
also be observed. The cells treated with orientin and vitexin
showed typical apoptotic morphological changes. The apoptotic
features were a shrunken cell body, brightly dyed nuclear
chromatin, nuclear fragmentation and the formation of apoptotic
bodies. The number of apoptotic cells increased gradually in a
concentration-dependent manner. The activity of vitexin (Fig. 3) was lower than that of orientin
(Fig. 4) at the same dose.
Effect of orientin and vitexin on the
DNA of EC-109 cells
The results showed a marked difference in the DNA
bands of control groups (lanes B and G) in comparison to those
treated with orientin (lanes C-E) or vitexin (lanes H-J). The
results showed that a DNA ladder could not be visualized in the
blank control group, however, discrete DNA bands were observed in
the treated groups, particularly for the groups treated with 80.0
µM orientin or vitexin. The ladders in the groups exposed to 20.0
and 5.0 µM of each agent were fuzzy and dark, however, the bands
were obvious. The DNA ladder of the cells exposed to orientin was
brighter than that of the cells exposed to vitexin at the same
concentrations, whereas the differences are not apparent (Fig. 5). These results indicated that
orientin and vitexin induced cell apoptosis, in a dose-dependent
manner, and the efficacy of orientin was higher than that of
vitexin.
Effect of orientin and vitexin on
EC-109 cell apoptosis rate
The Annexin V-FITC/PI double staining method was
adopted and the detection results indicated that orientin and
vitexin at different concentrations could induce the apoptosis of
the EC-109 cells; the apoptosis rate was dose-dependent. The
apoptosis rate differed significantly for the various
concentrations used in the orientin-treated group (P<0.05).
Similar results were found for the vitexin-treated group. The cell
apoptosis rates showed a significant increase in the drug-treated
groups compared with the control group (P<0.01). The EC-109
apoptotic rate following orientin treatment was 28.03%, whereas
following treatment with vitexin, this rate was 12.38% (P<0.01)
(Table II). The FCM detection
results are presented in Figs. 6 and
7.
 | Table II.Effect of different concentrations of
orientin and vitexin on EC-109 cell apoptosis (mean ± standard
deviation; n=3). |
Table II.
Effect of different concentrations of
orientin and vitexin on EC-109 cell apoptosis (mean ± standard
deviation; n=3).
|
| Apoptotic rate,
% |
|---|
|
|
|
|---|
| Group | 5.0 µM | 20.0 µM | 80.0 µM |
|---|
| Orientin |
3.36±0.20a–c |
7.21±0.34a–c |
28.03±0.64a–c |
| Vitexin |
1.68±0.15a–c |
3.83±0.22a–c |
12.38±0.42a–c |
|
Controld |
|
0.64±0.12 |
|
Effect of orientin and vitexin on p53
and bcl-2 in EC-109 cells
When comparing EC-109 cells exposed to different
concentrations of drugs for 48 h with the blank control group, the
expression of p53 was significantly increased (P<0.01).
Conversely, the expression of bcl-2 in the EC-109 cells was
significantly decreased (P<0.01). These changes were
dose-dependent. Compared with vitexin, orientin played
significantly a greater role in affecting the expression of p53 and
bcl-2 in the EC-109 cells (P<0.01; Table III).
 | Table III.Effects of p53 and bcl-2 on EC-109
cells treated with different concentrations of orientin and vitexin
(mean ± standard deviation; n=5). |
Table III.
Effects of p53 and bcl-2 on EC-109
cells treated with different concentrations of orientin and vitexin
(mean ± standard deviation; n=5).
|
| p53, % | bcl-2, % |
|---|
|
|
|
|
|---|
| Concentration,
µM | Orientin |
| Vitexin | Orientin |
| Vitexin |
|---|
| 5.0 |
4.23±0.12a–c |
|
2.95±0.14a–c |
2.02±0.06a–c |
|
3.48±0.07b,c |
| 20.0 |
12.35±0.43a–c |
|
7.23±0.05a–c |
1.03±0.07a–c |
|
1.79±0.06a–c |
| 80.0 |
23.08±1.16a–c |
|
14.06±0.07a–c |
0.17±0.05a–c |
|
0.89±0.09a–c |
|
Controld |
|
1.74±0.11 |
|
|
3.61±0.13 |
|
Discussion
This study shows that at concentrations ranging
between 5.0 and 8.0 µM, orientin and vitexin inhibit esophageal
cancer cell growth in a dose-and time-dependent manner. Analysis of
the time-dose effect trends revealed that the high concentration
group plays a significant role in the early time periods, and
inhibition rate increased as concentration increased. However, the
inhibition rate was not directly proportionate to the dose. At
different time-points, the inhibition rate by orientin and vitexin
at the same concentration showed time dependence. However, the
inhibition rate was not directly proportional to time. When
comparing the inhibition rate of 48 h to that of 24 h, there are
significant differences between the two. The same is true for 48
and 72 h. The results indicated that 48 h is the best timing for
research on the early apoptosis of EC-109. Hence, the drug exposure
time was fixed at 48 h in the following three experiments of cell
apoptosis detection.
In the early stages of cell apoptosis, the
degradation of DNA in the nucleus was under control, forming
different lengths of nucleic acid fragments; however, necrocytosis
and DNA degradation occurred in the later stages of apoptosis.
Thus, the emergence of a DNA ladder signified apoptosis. When
adopting the agarose gel electrophoresis and Hoechst 33258 staining
methods, the results showed that orientin and vitexin could inhibit
EC-109 cell growth and induce apoptosis, which was
concentration-dependent. FCM, which is not only used for
quantitative analysis but also for discrimination of necrotic
cells, is an authoritative testing method for analyzing cell
apoptosis (22). When adopting FCM,
the present study found that EC-109 cell apoptosis, induced by
orientin and vitexin, is dose-dependent. However, it is worth
noting that the number of dead cells increased as apoptosis
increased, as shown in the FCM detection image, which awaits
further research.
The concrete mechanism of cell apoptosis involves a
series of complex gene regulatory actions. In a previous study
(23), genes in cells relevant to
apoptosis were divided into two types: The apoptosis genes and the
anti-apoptosis genes. Drug-induced cell apoptosis and necrosis was
found to be regulated by one or more genes. Oncogenes existing in
normal cells take part in normal cell growth, differentiation and
metabolism. Anti-oncogenes are genes with the potential capacity to
inhibit carcinogenesis and could inhibit cancer cell growth
(24). Oncogene and tumor suppressor
genes play a role in tumor occurrence and development; oncogenes
could promote cancer cell proliferation, resulting in tumors, while
tumor suppressor gene could induce cancer cell apoptosis, eliminate
the cancer cells (25). The present
experimental results showed that orientin and vitexin upregulated
oncogene p53 expression and downregulated cancer-promoting gene
bcl-2 expression, and then induced apoptosis in the EC-109
cells.
In conclusion, the present study showed that
orientin and vitexin could inhibit cell growth and induce an early
apoptotic state in EC-109 cells. The effect of orientin was greater
than that of vitexin at the same concentration, which may or may
not be associated with the hydroxyl groups at the 3′ and 4′ of the
B ring in orientin compared with the single hydroxyl group at the
4′ of the B ring in vitrexin. It follows that orientin and vitexin
as flavone C-glycosides are likely to be a novel type of esophageal
cancer treatment, with good research and clinical application
prospects.
Acknowledgements
This study was financially supported by the Major
Scientific Projects of Hebei North University (grant no. ZD1314),
and was partly supported by the Technology Bureau of Zhangjiakou
(grant no. 11110015D).
References
|
1
|
Zhang XG: Risk factors and prevention
research progress of esophagus cancer. World Chin J Dig.
17:670–680. 2009.(In Chinese).
|
|
2
|
Li XK and Fan QX: The research progress of
esophageal cancer drug therapy. World Chin J Dig. 35:3482–3487.
2012.(In Chinese).
|
|
3
|
Kelsen D, Ajani J, Ilson D, Daugherty K
and Pazdur R: A phase ii trial of paclitaxel (Taxol) in advanced
esophageal cancer: Preliminary report. Semin Oncol. 5:(Suppl 8).
44–48. 1994.
|
|
4
|
Li LQ: The geographical distribution of
buttercup family of Trollius chinensis. Acta Phytotaxonomica
Sinica. 33:535–537. 1995.(In Chinese).
|
|
5
|
Li YL, Ye SM, Wang LY and Cen YZ:
Isolation and biological activity of proglobeflowery acid from
Trollius chinensis Bunge. J Jinan Univ. 23:124–126. 2002.(In
Chinese).
|
|
6
|
Shen ZP: Traditional Chinese medicine
pharmaceutical research and application of Trollius
chinensis. Lishizhen Med Mater Med Res. 11:1110–1113. 2000.(In
Chinese).
|
|
7
|
Su LJ, Tian H and Ma YL: Trollius
chinensis Bunge ethanol-extraction objects in experimental
study of antiviral effect. Chin Herb Med. 38:1062–1064. 2007.(In
Chinese).
|
|
8
|
Sun L, Liu F, Liu H, Luo Q and An F: The
effects of Trolliusflavonoids on human breast cancer cells.
J Chin G. 29:1098–1099. 2009.(In Chinese).
|
|
9
|
Sun L, Cheng JZ, Luo Q, Zhang XC, Bai XM
and An F: Effects of Trollius flavonoids on proliferation of
K562, HeLa, Ec-109 and NCI-H446 tumor cells. Med J Zhengzhou Univ.
44:981–983. 2009.(In Chinese).
|
|
10
|
Sun L, Luo Q, Zhang L, Hao XQ, Liu H, Tian
JM and An F: Effects of Trollius flavonoids on growth and apoptosis
of A549 cells. J Chin G. 31:82–83. 2011.(In Chinese).
|
|
11
|
Su LJ, Wang H and Su ZW: Chemical
component and pharmacology of Trollius. World Notes Plant
Med. 20:14–16. 2005.(In Chinese).
|
|
12
|
Kang SW and Yu YF: The research on
Trollius chemical component. Chin Herb Med. 15:7–9. 1984.(In
Chinese).
|
|
13
|
Liu LJ, Wang XK and Kuang HX: Study on the
chemical composition of leaves and stalks of Trollius
macropetalus. Yao Xue Xue Bao. 27:837–840. 1992.(In Chinese).
PubMed/NCBI
|
|
14
|
Fu XC, Li SP, Wang XG and Yan Z: Research
on antithrombotic effect of orientin. China Pharm. 17:1292–1293.
2006.(In Chinese).
|
|
15
|
Yang GD, Rao N and Tian JM: The study on
antioxidant effect of orientin and vitexin from Trollius
chinensis. Lishizhen Med Mater Med Res. 22:2172–2173. 2011.(In
Chinese).
|
|
16
|
Fu XC, Wang X and Zheng H: The protective
effect of orientin on ischemic and anoxic myocardial cells. J Sou
Med Univ. 127:1173–1175. 2007.(In Chinese).
|
|
17
|
Yang GD, Rao N, Tian JM, An F and Wang SH:
Study on antioxidation of orientin and vitexin from Trollius
chinensis. Lishizhen Med Mater Med Res. 22:2172–2173. 2011.(In
Chinese).
|
|
18
|
Zhang X: Research progress of vitexin
pharmacologic action. China Med Hed. 10:35–42. 2013.(In
Chinese).
|
|
19
|
Chang W: The structure-activity
relationship and ROS related mechanism of anti-cancer effect of
flavonoids. Chongqing: TMMU; 2008, (In Chinese).
|
|
20
|
Wu XA, Qin F and Du MQ: Quantitative
structure and anti- inflammatory activity relationship preliminary
discussion of flavone-C glycosides. Lishizhen Med Mater Med Res.
23:632–633. 2012.(In Chinese).
|
|
21
|
Wu XA, Qing F and Du MQ: The QSAR study on
anti-inflammatory activities of C-glycosy flavones. Lishizhen Med
Mater Med Res. 23:632–633. 2012.(In Chinese).
|
|
22
|
Lamm GM, Steinlein P, Cotten M and
Christofori G: A rapid, quantitative and inexpensive method for
detecting apoptosis by flow cytometry in transiently transfected
cells. Nucleic Acids Res. 23:4855–4857. 1997. View Article : Google Scholar
|
|
23
|
Lu W: The mechansim of shikonin-induced
apoptosis in MCF-7 breast cancer. Jilin Univ. 17–23. 2013.(In
Chinese).
|
|
24
|
Peng L, Qi FL and Yin YH: New approach of
oncotherapy - Chinese medicine ingredients induced differentiation
of malignant cell. B Bio. 37:8–11. 2002.(In Chinese).
|
|
25
|
EI-Aneed A: Current strategies in cancer
gene therapy. Eur J Pharm. 498:1–8. 2004. View Article : Google Scholar
|